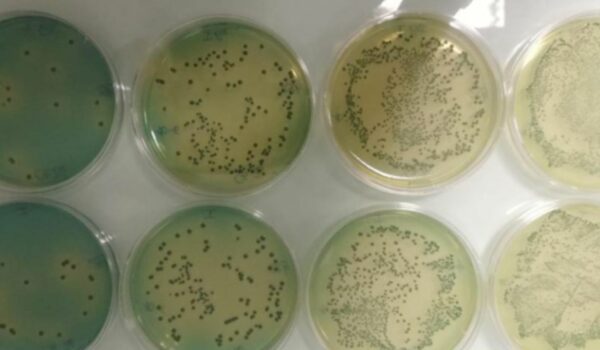

Storie
Omer Spa: a Carini un polo produttivo innovativo per la green mobility
OMER, Officine Meccaniche Russello, è stata fondata a Palermo nel 1990, oggi è un importante operatore a livello internazionale nel settore della progettazione e realizzazione di component...
Leggi la storiaProgetti di matrice digitale all’Università di Palermo
L'Università degli Studi di Palermo ha presentato diversi progetti di matrice digitale riguardanti ambiti tecnologici e funzionali, realizzate grazie all'impegno dell'Autorità Regionale pe...
Leggi la storiaNo Fire Nave: rivestimenti innovativi, ecologici e antifiamma per imbarcazioni
L’idea progettuale di No Fire Nave è nata dall’esigenza e dalla volontà industriale di sviluppare vernici innovative e maggiormente sostenibili per l’impiego navale, portuale e canti...
Leggi la storiaSi-Mare, soluzioni innovative per mezzi navali
Si-Mare nasce dalla collaborazione tra grandi aziende del settore navale, università e centri di ricerca e ha permesso di portare all’interno dell’industria nautica, attraverso applicaz...
Leggi la storiaDigidel, tecnologie di deumidificazione intelligenti al servizio del patrimonio architettonico
Il progetto Digidel, acronimo di “Dispositivo di Gestione Intelligente per Sistemi di Deumidifica-zione Elettrofisici”, si inquadra nell’ambito delle soluzioni innovative per lo Smart ...
Leggi la storiaNonSacWine: a Marsala un progetto di innovazione per il settore enologico
Il progetto NonSacWine, sviluppato da HTS Enologia di Marsala, con i partners Co.El.Me. s.n.c. e Ri.Fra. s.r.l., ha portato avanti uno studio per l’impiego nel settore enologico di ceppi d...
Leggi la storiaSmartep: uno smart energy parking innovativo nel campus universitario di Palermo
SMARTEP - Sustainable Model And Renewable Thinking Energy Parking - prevede la definizione, la progettazione e la realizzazione, all’interno del Campus dell’Università degli Studi di Pa...
Leggi la storiaPlanning the future: innovazioni tecnologiche per il Liceo Lucio Piccolo di Capo d’Orlando
Innovazioni tecnologiche per la valorizzazione delle risorse umane, finalizzate al rinnovamento della didattica e della formazione: una missione, quella del Liceo Lucio Piccolo di Capo d’O...
Leggi la storiaTraiprolac, nuove tecnologie e nuovi disciplinari di produzione per le aziende lattiero-casearie
Il progetto Traiprolac, realizzato con il contributo del PO FESR 2014-2020, punta a definire nuovi processi di produzione per le aziende lattiero-casearie, fornendo nuovi strumenti che conse...
Leggi la storia